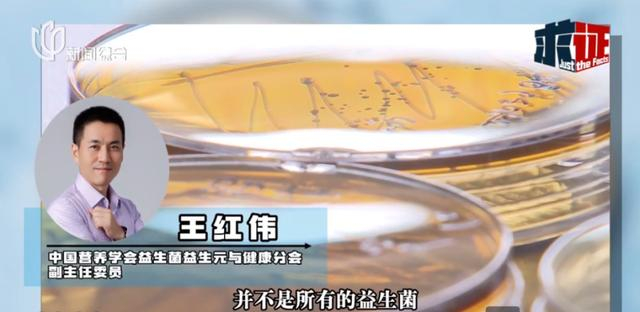

最近,某现制酸奶品牌推出的“畅”系列酸奶,成为不少人口中的“新型泻药”。

腹泻、拉肚子是最常见的情况,还有消费者表示,自己出现腹痛、发烧等症状,甚至因肠胃炎大半夜进了急诊。


查询黑猫投诉等平台可以发现,该品牌早在2022年就曾接到过类似投诉。投诉人表示,饮用后出现肚子疼痛不适,次日早上出现上吐下泻发烧症状,就医后确诊为急性肠胃炎。


为了验证这一情况,记者也点了这杯售价45元的高端酸奶。
记者看到,瓶身的标签特别显眼,除了品名、购买时间等信息外,还列出了各种益生菌和一些添加成分,“喝起来,整体口感偏酸,但并没有明显不同。”

记者下午2点多喝下酸奶后,4小时开始出现腹泻症状,断断续续跑了四五次厕所,直到第二天接近10点时仍在腹泻。“据了解,我的两名同事也出现了不同程度的腹泻。”

值得一提的是,该酸奶的商品介绍页明确提醒:肠胃消化功能弱者,建议不食用本品。然而,消化功能弱者有什么标准?为什么会出现这样的腹泻情况呢?

记者询问门店工作人员,对方称:这款喝的,每个人都会拉肚子。

官方信息显示,该系列酸奶每杯的活性益生菌为5000亿(出品时),其中添加了3瓶所谓的“小蓝瓶1号”,也就是店员所说的具有通便功效的酸奶。

此外,小蓝瓶的营养成分表显示,其膳食纤维含量为13.5g/100ml,按3瓶计算,这杯酸奶至少含有40.5g的膳食纤维。这是不是产生腹泻的直接原因呢?

医生表示,这杯酸奶中的益生菌含量几乎是每日推荐量(10亿~50亿)的100倍,膳食纤维含量也超出了每日20克~40克的上限。
上海交通大学医学院附属仁济医院临床营养科主任医生徐仁应表示:“它这个益生菌含量号称有5000亿,确实已经明确地超出了常规的剂量。对于膳食纤维来说,成年人的剂量也是只有到20克~40克每天,那么它这个一杯的这个产品的量已经40多克,再加上其他的食物中还有膳食纤维,确实有可能造成肠蠕动过快,或者出现腹泻的情况。”

营养学家也表示,适量补充会增强结肠发酵作用,但如果发酵太剧烈,就会腹胀、腹痛甚至腹泻。益生菌益生元并不是越多越好,也并不是所有的都有通便的作用。如果腹泻率高,就要考虑食用其它食物的先后顺序,以及酸奶是否卫生、是否有致病菌污染。
中国营养学会益生菌益生元与健康分会副主任委员王红伟表示:“我们这个肠道里,尤其是大肠有大量的微生物,它主要的作用其实就是我们常说的结肠发酵,我们吃进去的膳食纤维和益生元,其实不能直接被消化,而是到大肠里被这些肠道的菌群给发酵利用了。适量补充益生菌或益生元,直观的一个表现就是结肠发酵作用的增强。但是,如果说发酵太剧烈,它就会让人产生腹胀、腹痛这些症状,甚至引起腹泻。当然,除了数量上的差别,各种益生菌和益生元的发酵特性也会有差别。所以,益生菌、益生元并不是越多越好,也不是各种益生菌、益生元的作用都一样!”

为了求证这一说法,记者尝试送检,但多家检测机构都表示,该酸奶属于现制现售类食品,在监管方面还没有明确的检验标准和规定。尤其涉及到微生物检测,干扰项多、难度较大,所以无法进行独立检测。

此外,专家也提醒,造成腹泻的原因多种多样,除了活性乳酸菌和膳食纤维含量外,还需考虑其他因素的影响。
医生介绍,若是腹泻,第一个考虑的原因是腹泻的发生率高不高,如果发生率比较高,要考虑是不是因为制作酸奶的卫生条件,有可能有其他的一些致病菌污染的情况。第二种情况是食物服用的时间先后顺序,要根据其他食物食用的先后顺序,考虑是否能耐受的情况。

实际上,以“活跃肠道”为卖点的活性乳酸菌饮料在市场中并不少见。以三款主流产品为例,标称的活性益生菌含量在百亿至千亿级别,个别产品甚至达到3000多亿,但并没有听说喝完后有普遍腹泻的情况。就此来看,标称数据和通便功效究竟是不是直接关联的呢?

营养学家介绍:“什么益生菌有通便的作用,服用多少量会起作用,这个都是要通过研究来证实的。但是我们在现实中,很少看到一个产品会去做一个临床实验,对饮料和酸奶,也没有这个法规的要求。”
专家透露,实际上可能还有一些“文字游戏”的成分:“厂家称生产时添加多少益生菌,或者是说出厂检测的时候是这么多,但是并没有保证产品到消费者手里或被消费者吃到肚子里的时候还有这么多。”另外,益生菌是指那些对人健康有益的菌株,包括多种菌株,各菌株作用不尽相同,并不是所有的益生菌都有通便的作用。

近年来,为了凸显酸奶的活菌作用,越来越多的品牌陆续打出“高含量”“新菌种”等营销牌,对比国家标准每百毫升酸奶的活性乳酸菌数量不可少于100万个(即≥1×10[gf]2076[/gf]CFU/100ml)的规定,新产品已普遍达到百亿级,向千亿级迈进。
除此以外,“常温活性菌”“明星乳酸菌”等新奇概念也不断吸引消费者的眼球。业内人士表示,目前国内益生菌产业正处于快速发展期,随之而来的监管空白,还需进一步研究、完善。

值得注意的是,在社交平台还流传着“拉肚子就能减肥”的说法,似乎只要勤腹泻,就不会储存食物中的脂肪和营养。
专家表示,这种说法并无道理,不应轻信任何打着“通便功效”的减肥产品。

上海交通大学医学院附属仁济医院临床营养科科主任徐仁应表示,“拉肚子以后确实是体重减轻了,但这个短期的体重减轻更多的是水分的丢失,而不是我们想要达到的减重或者减脂肪的目的。如果说拉肚子的时间过长,症状比较严重,除去水分丢失以外,还可能出现电解质紊乱的情况。所以医生还是要强调, 最好还是采用营养、运动、心理等等综合措施来达到控制体重的效果。”
来源:“新闻坊”微信公众号


